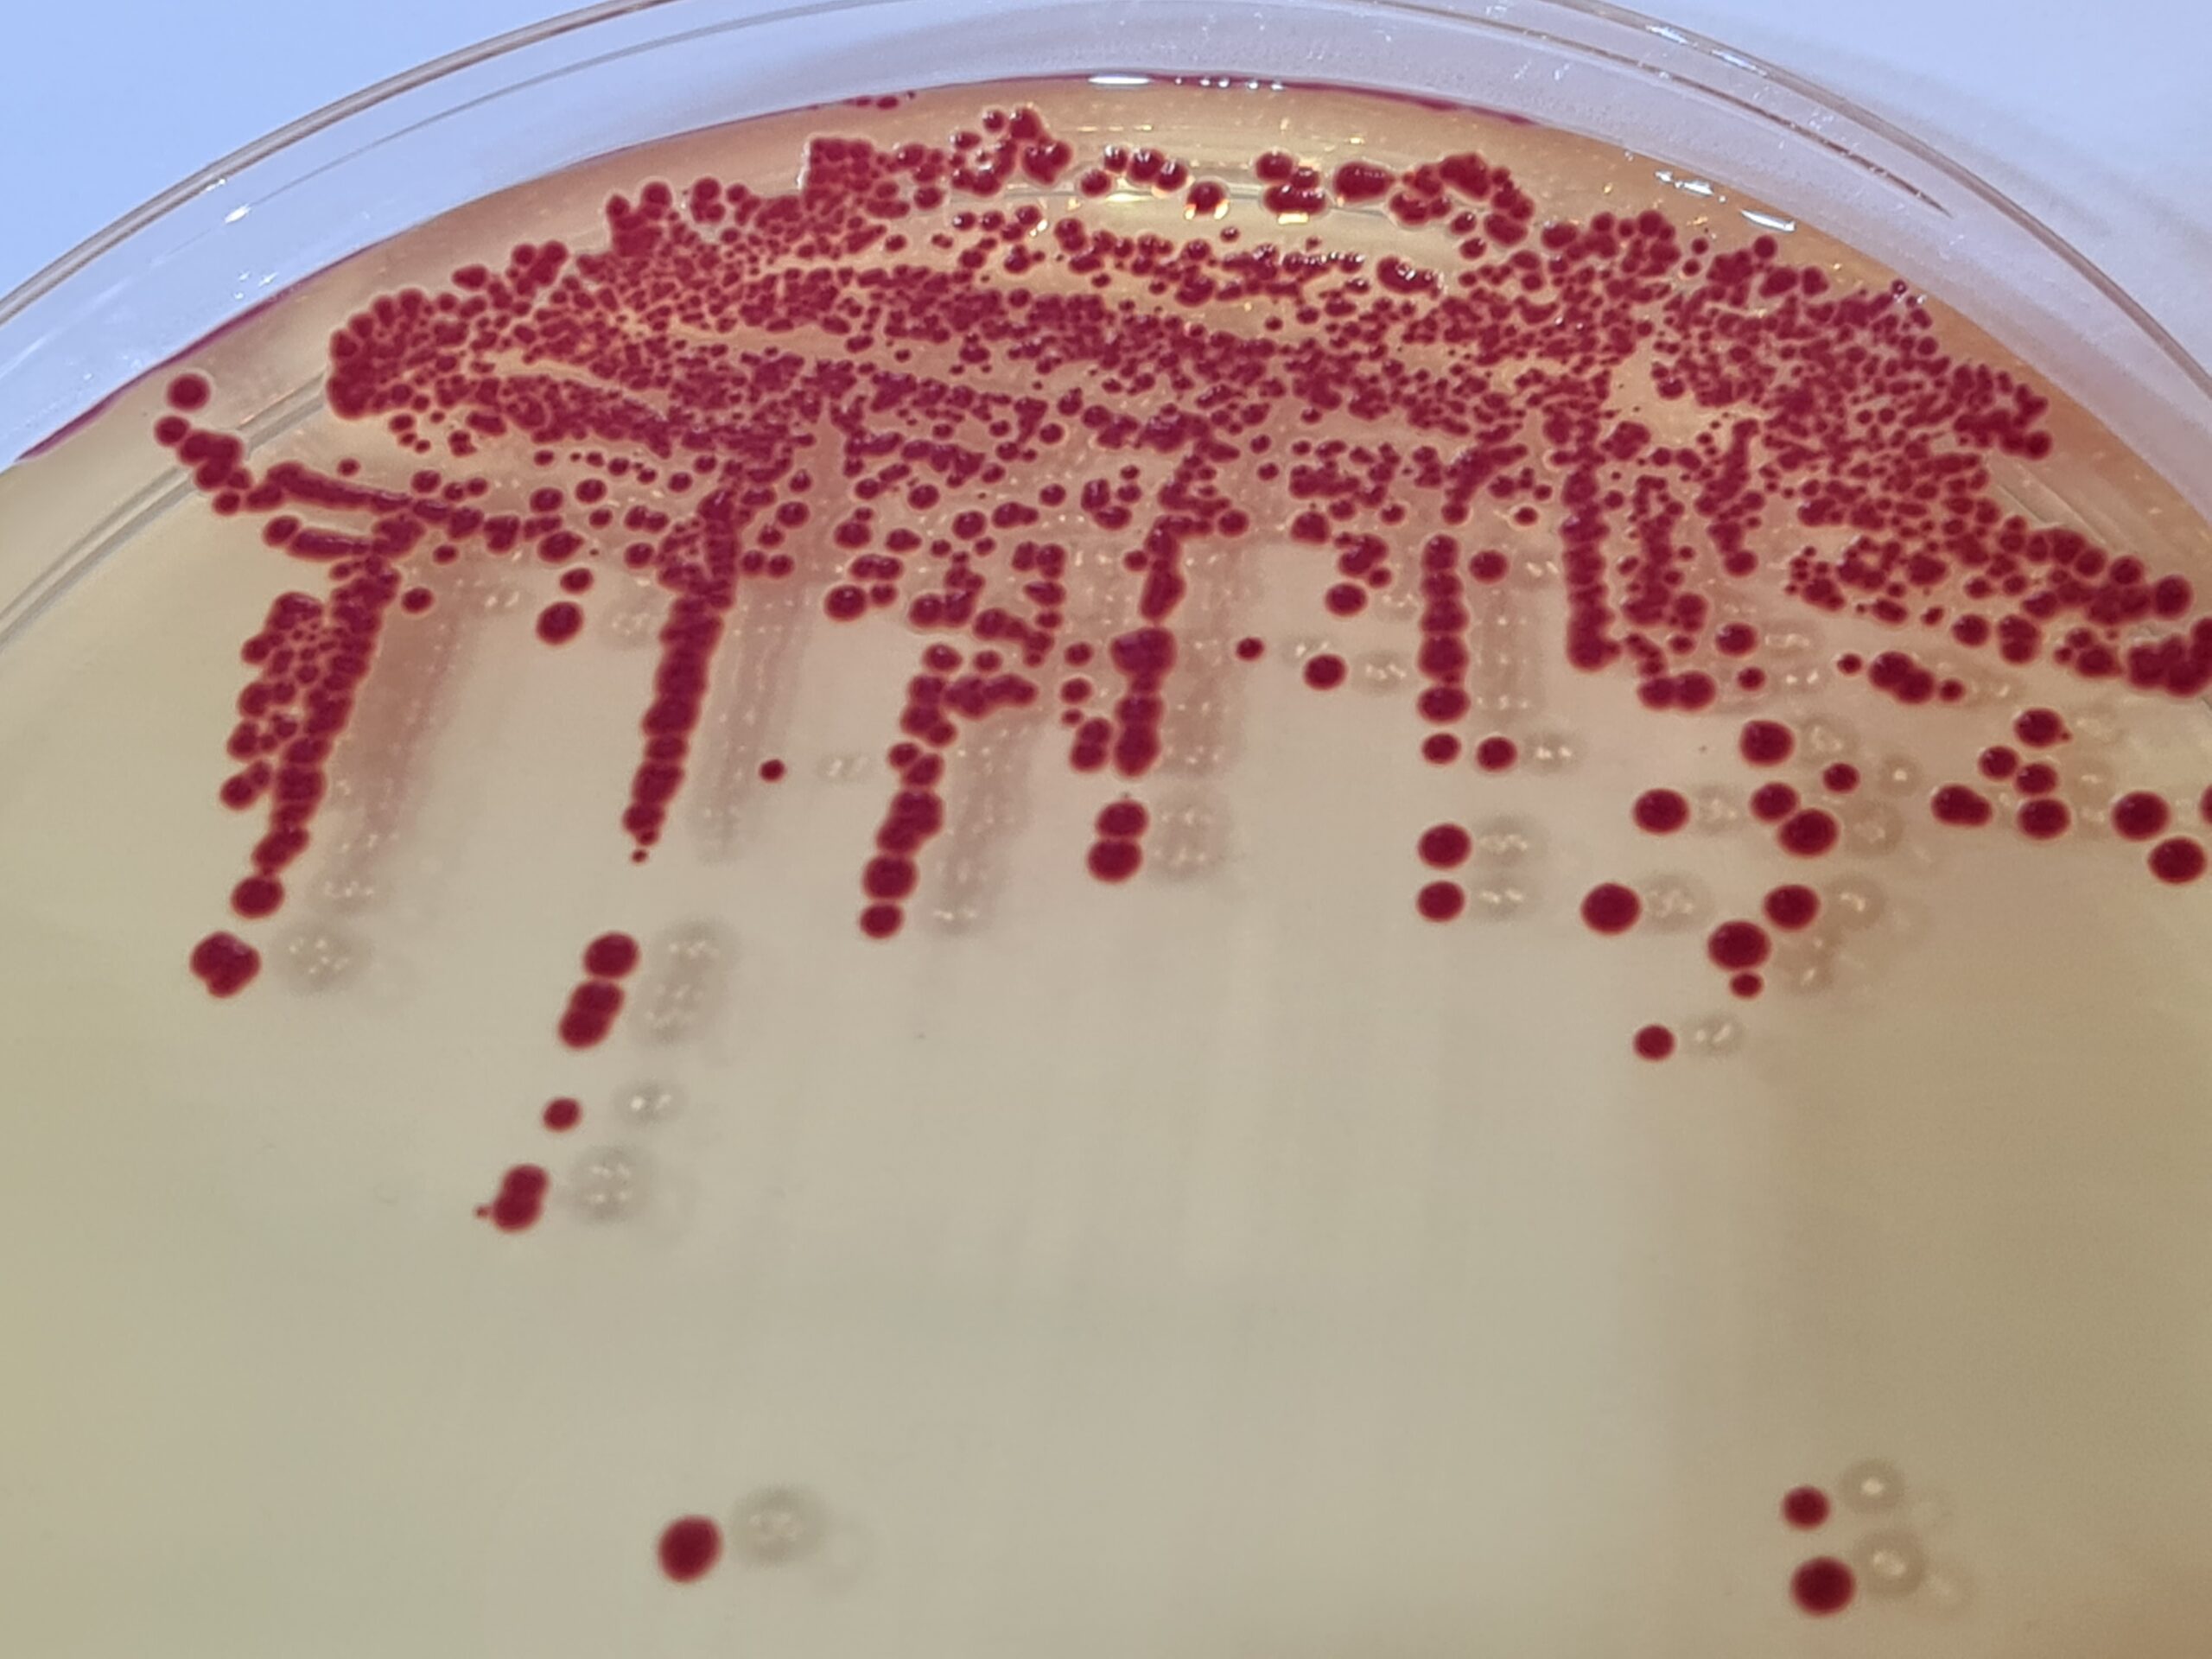
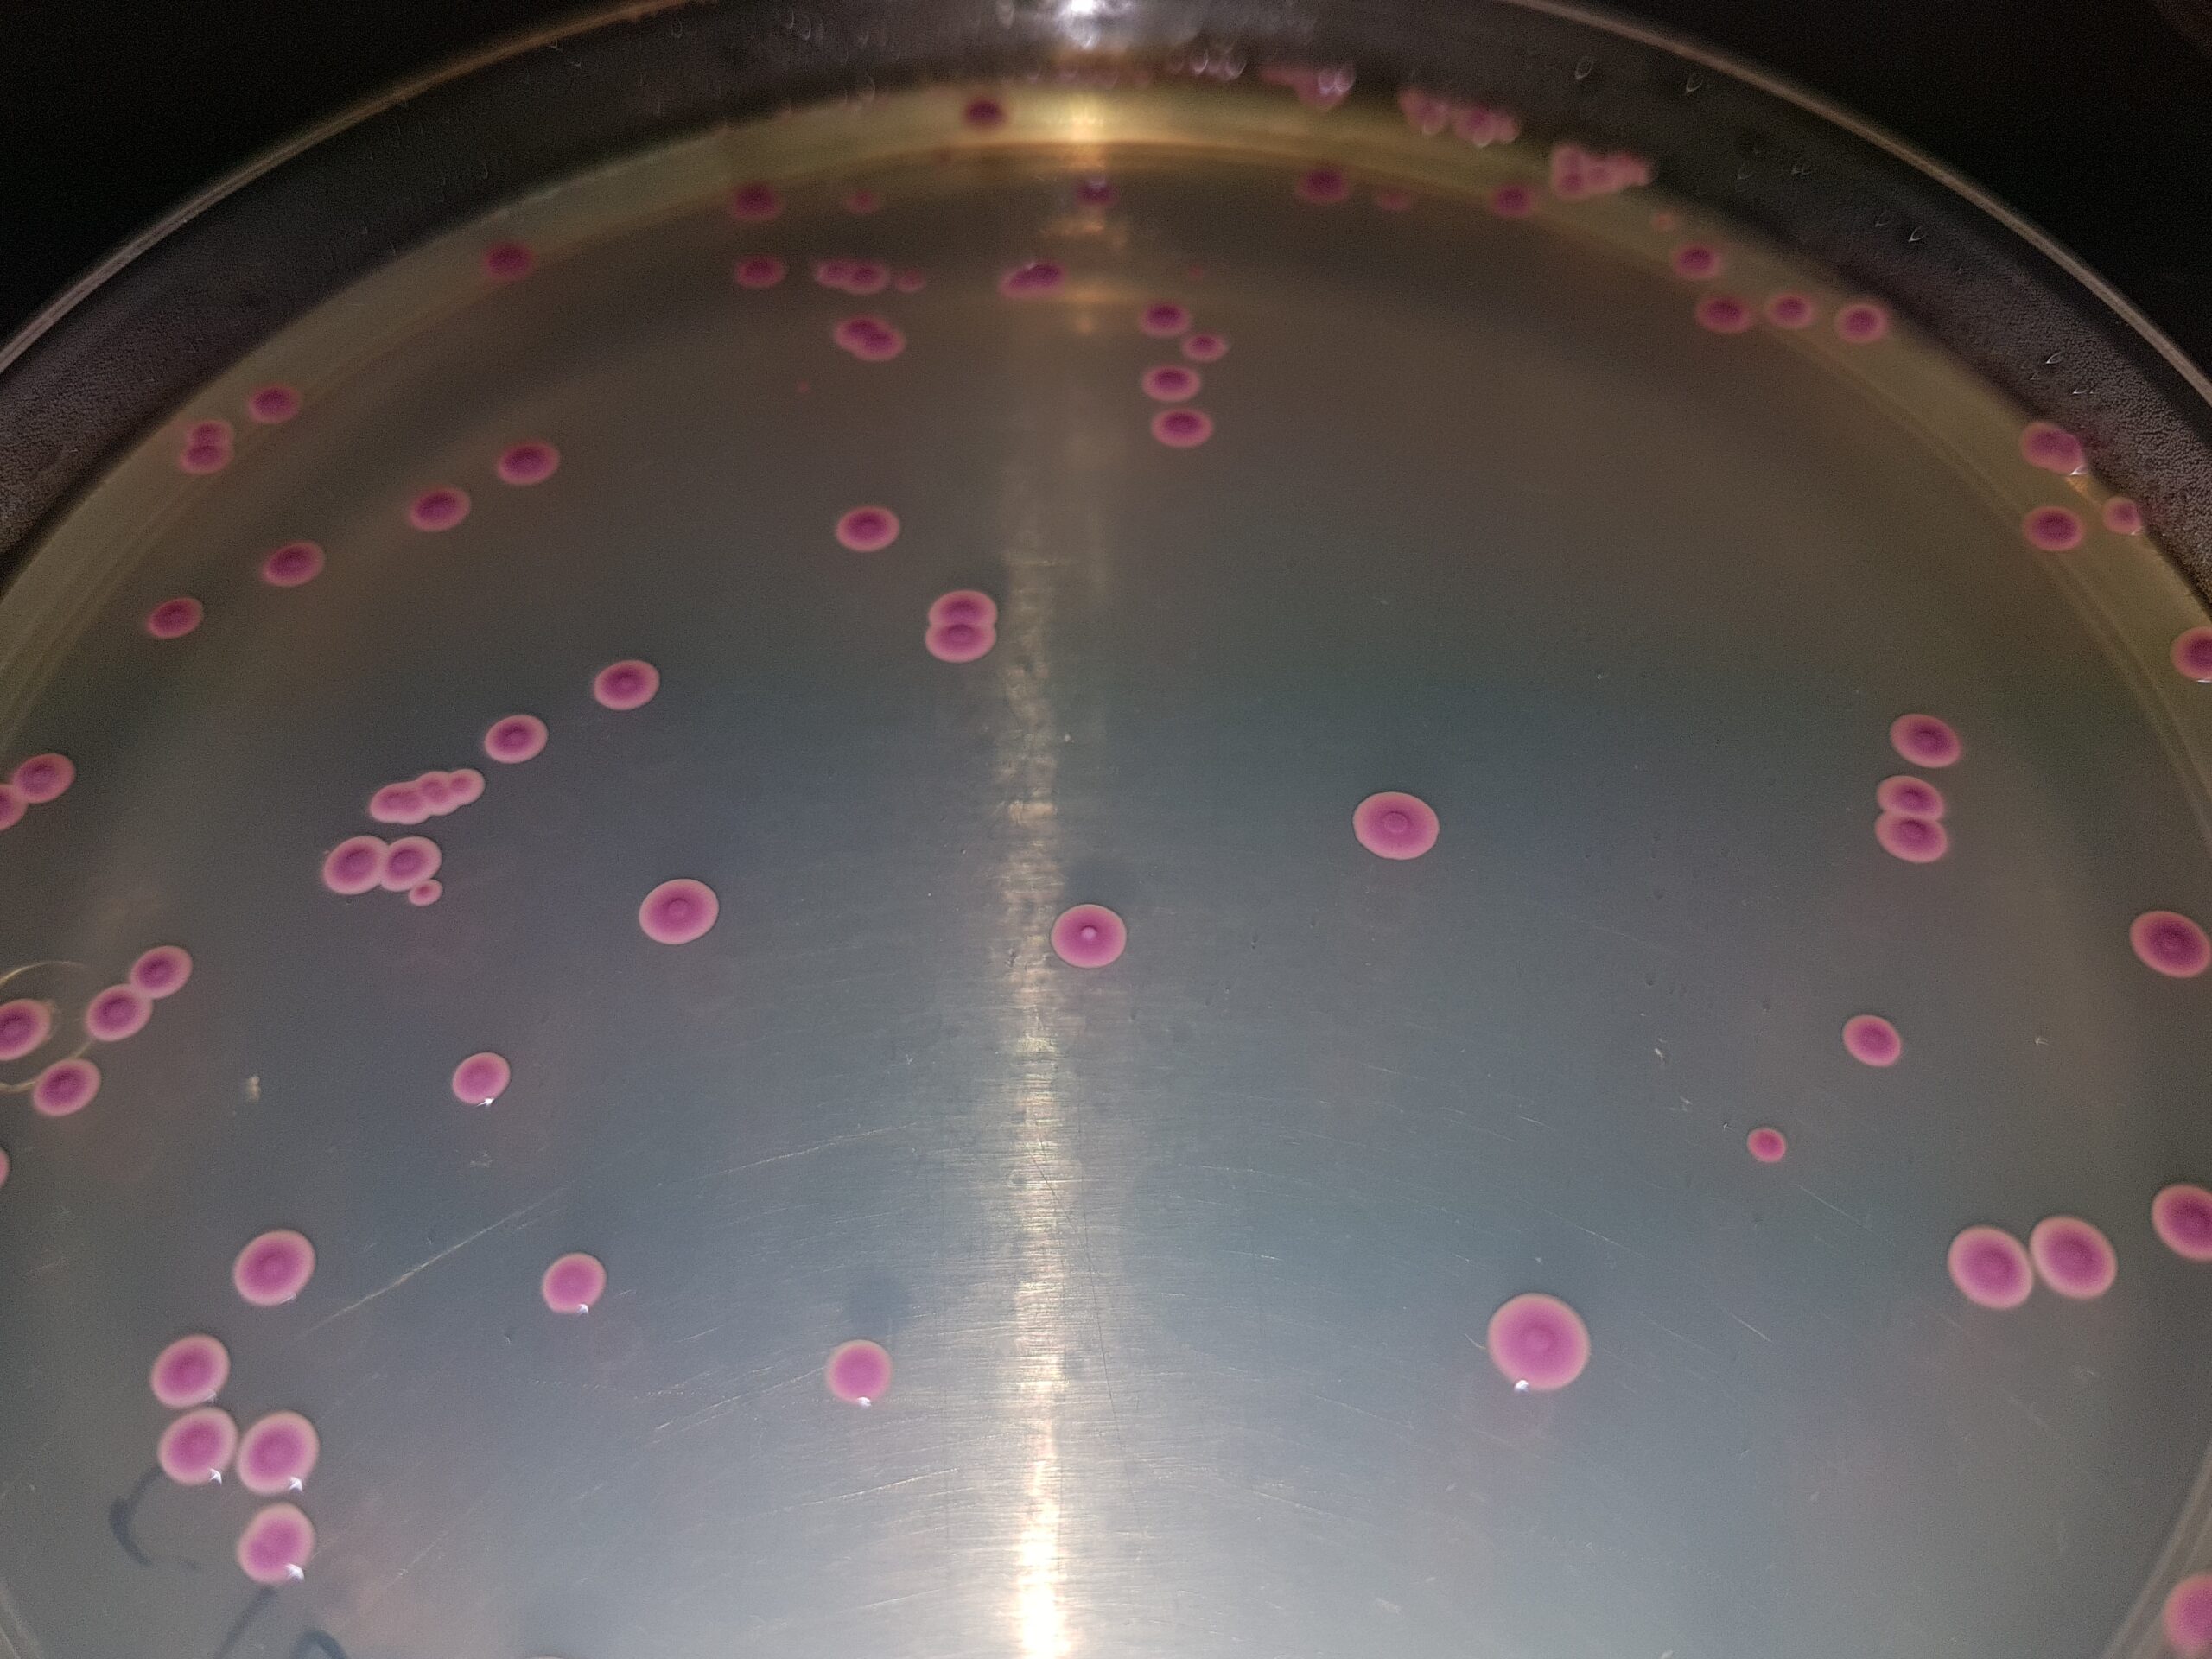
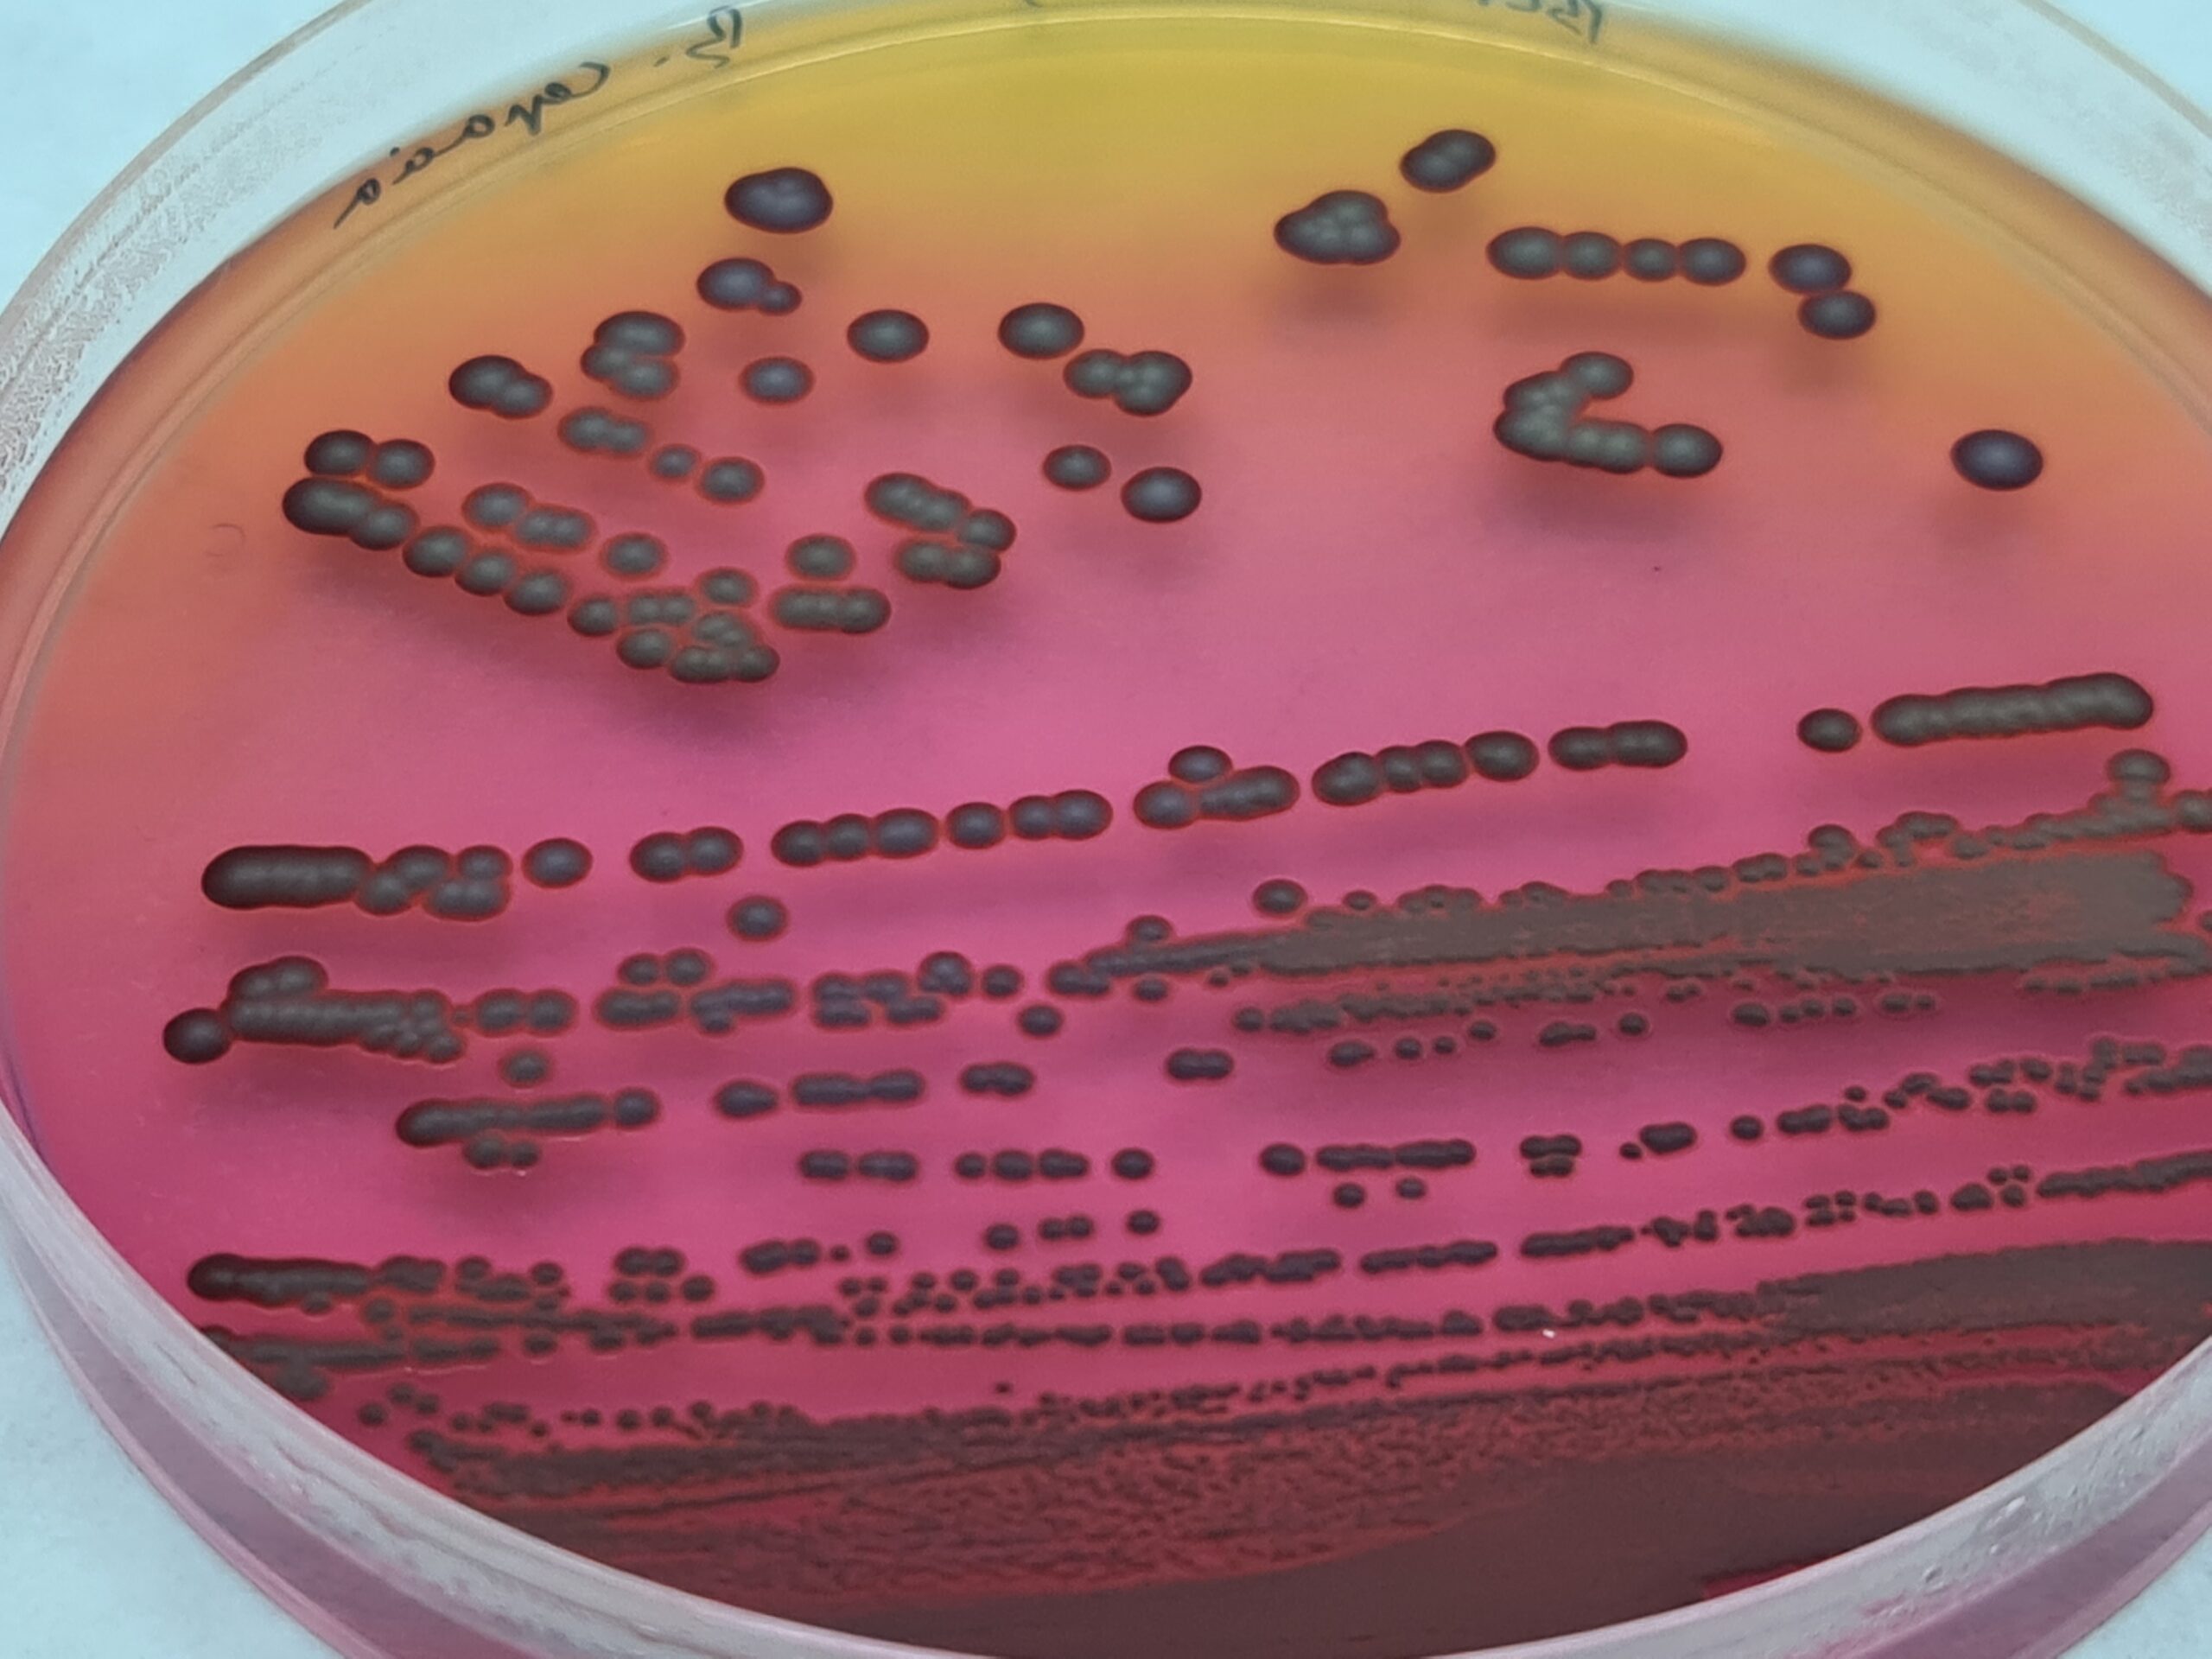
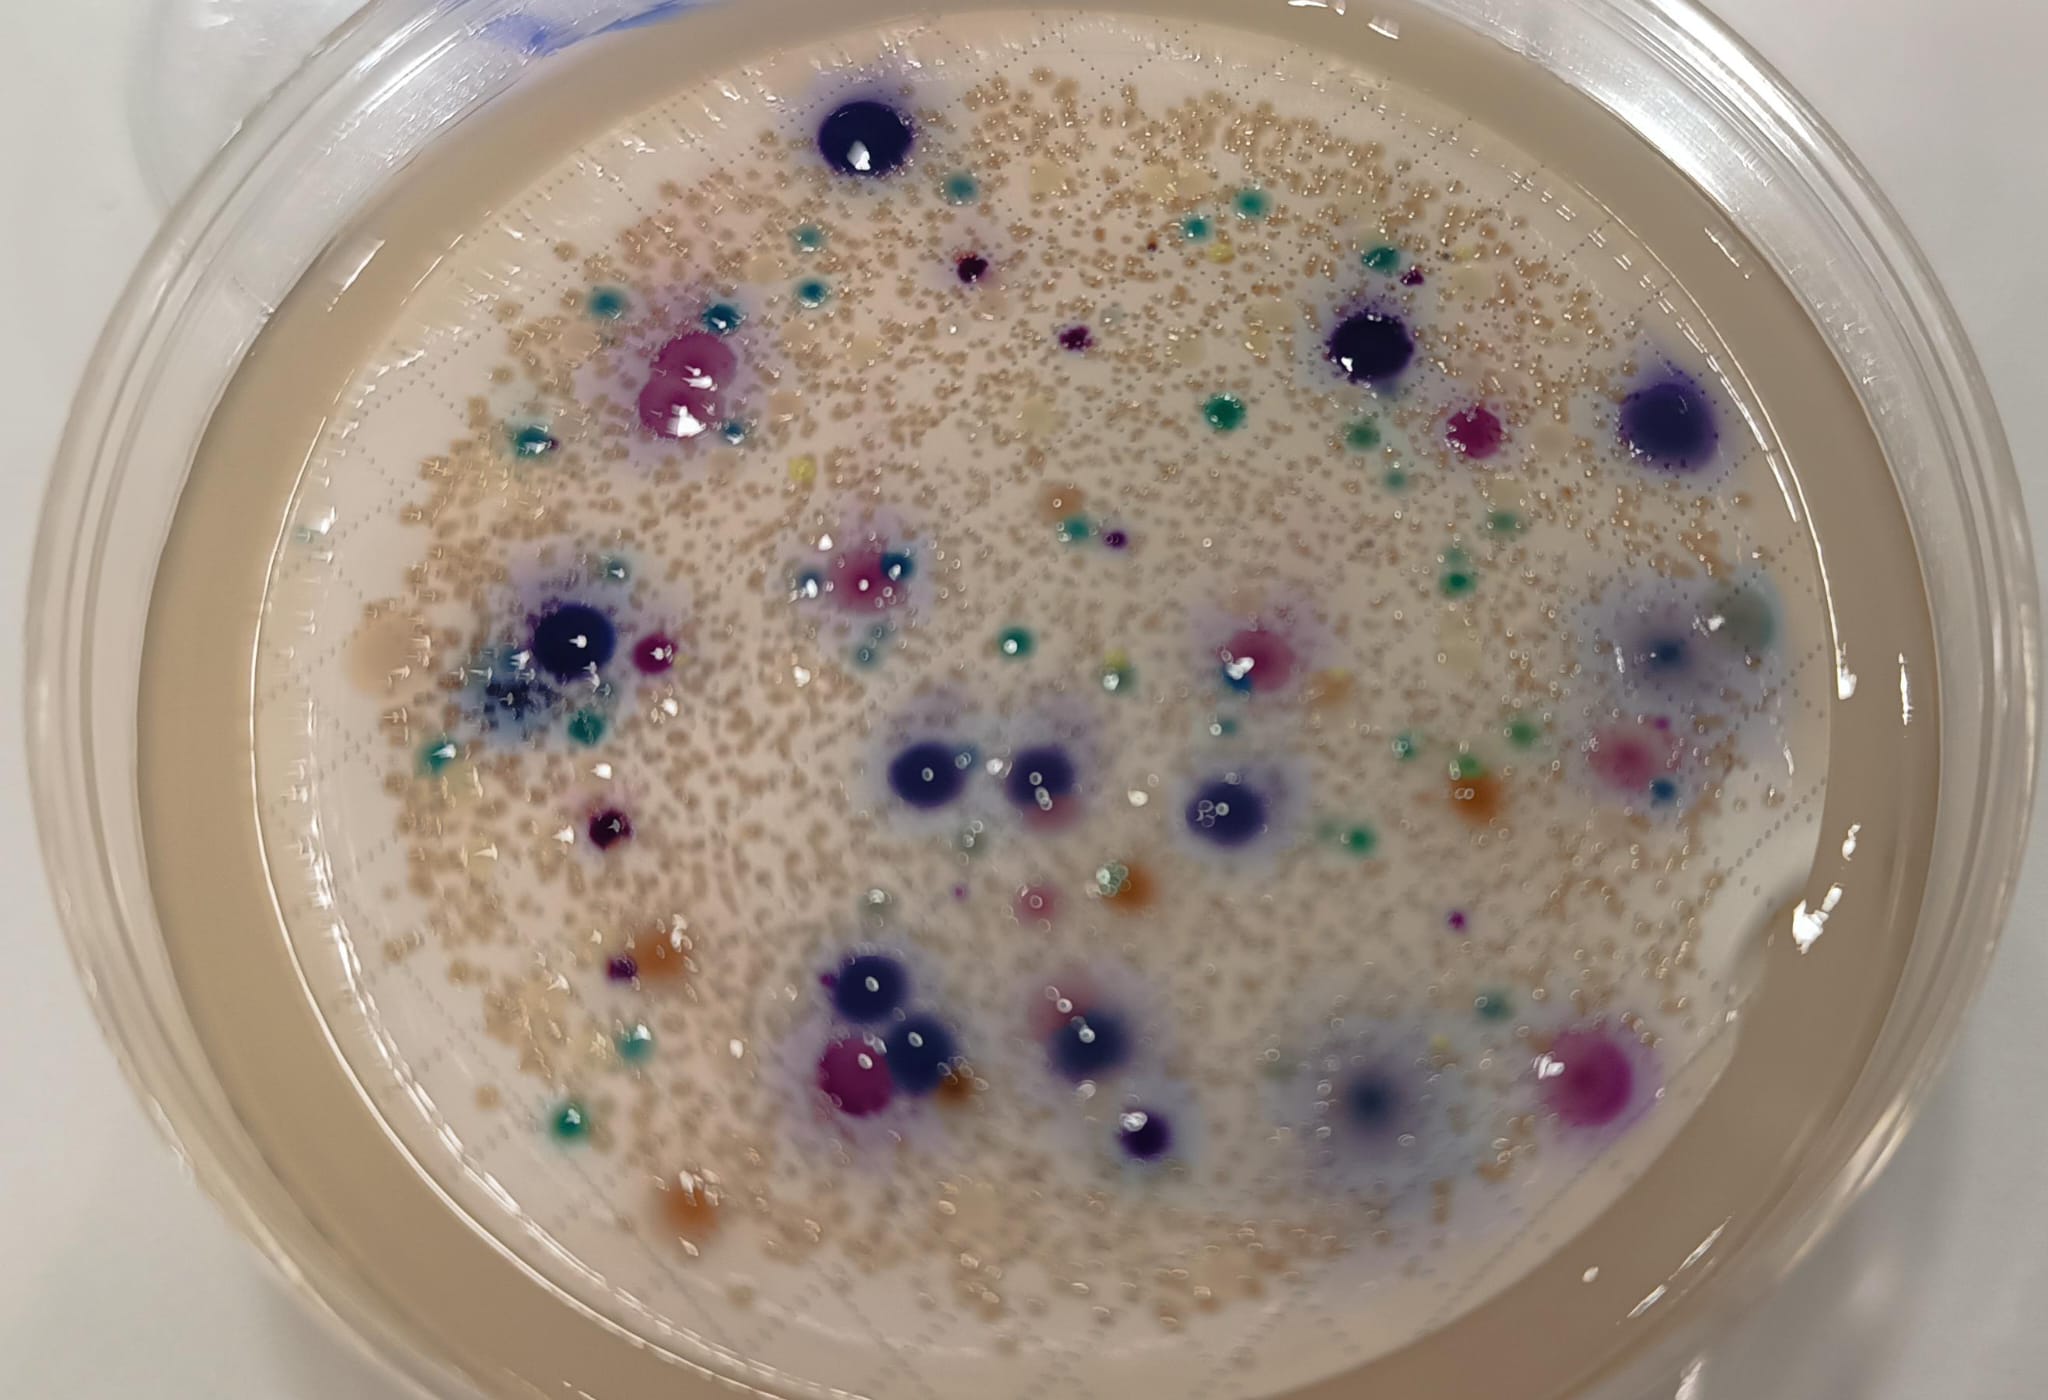
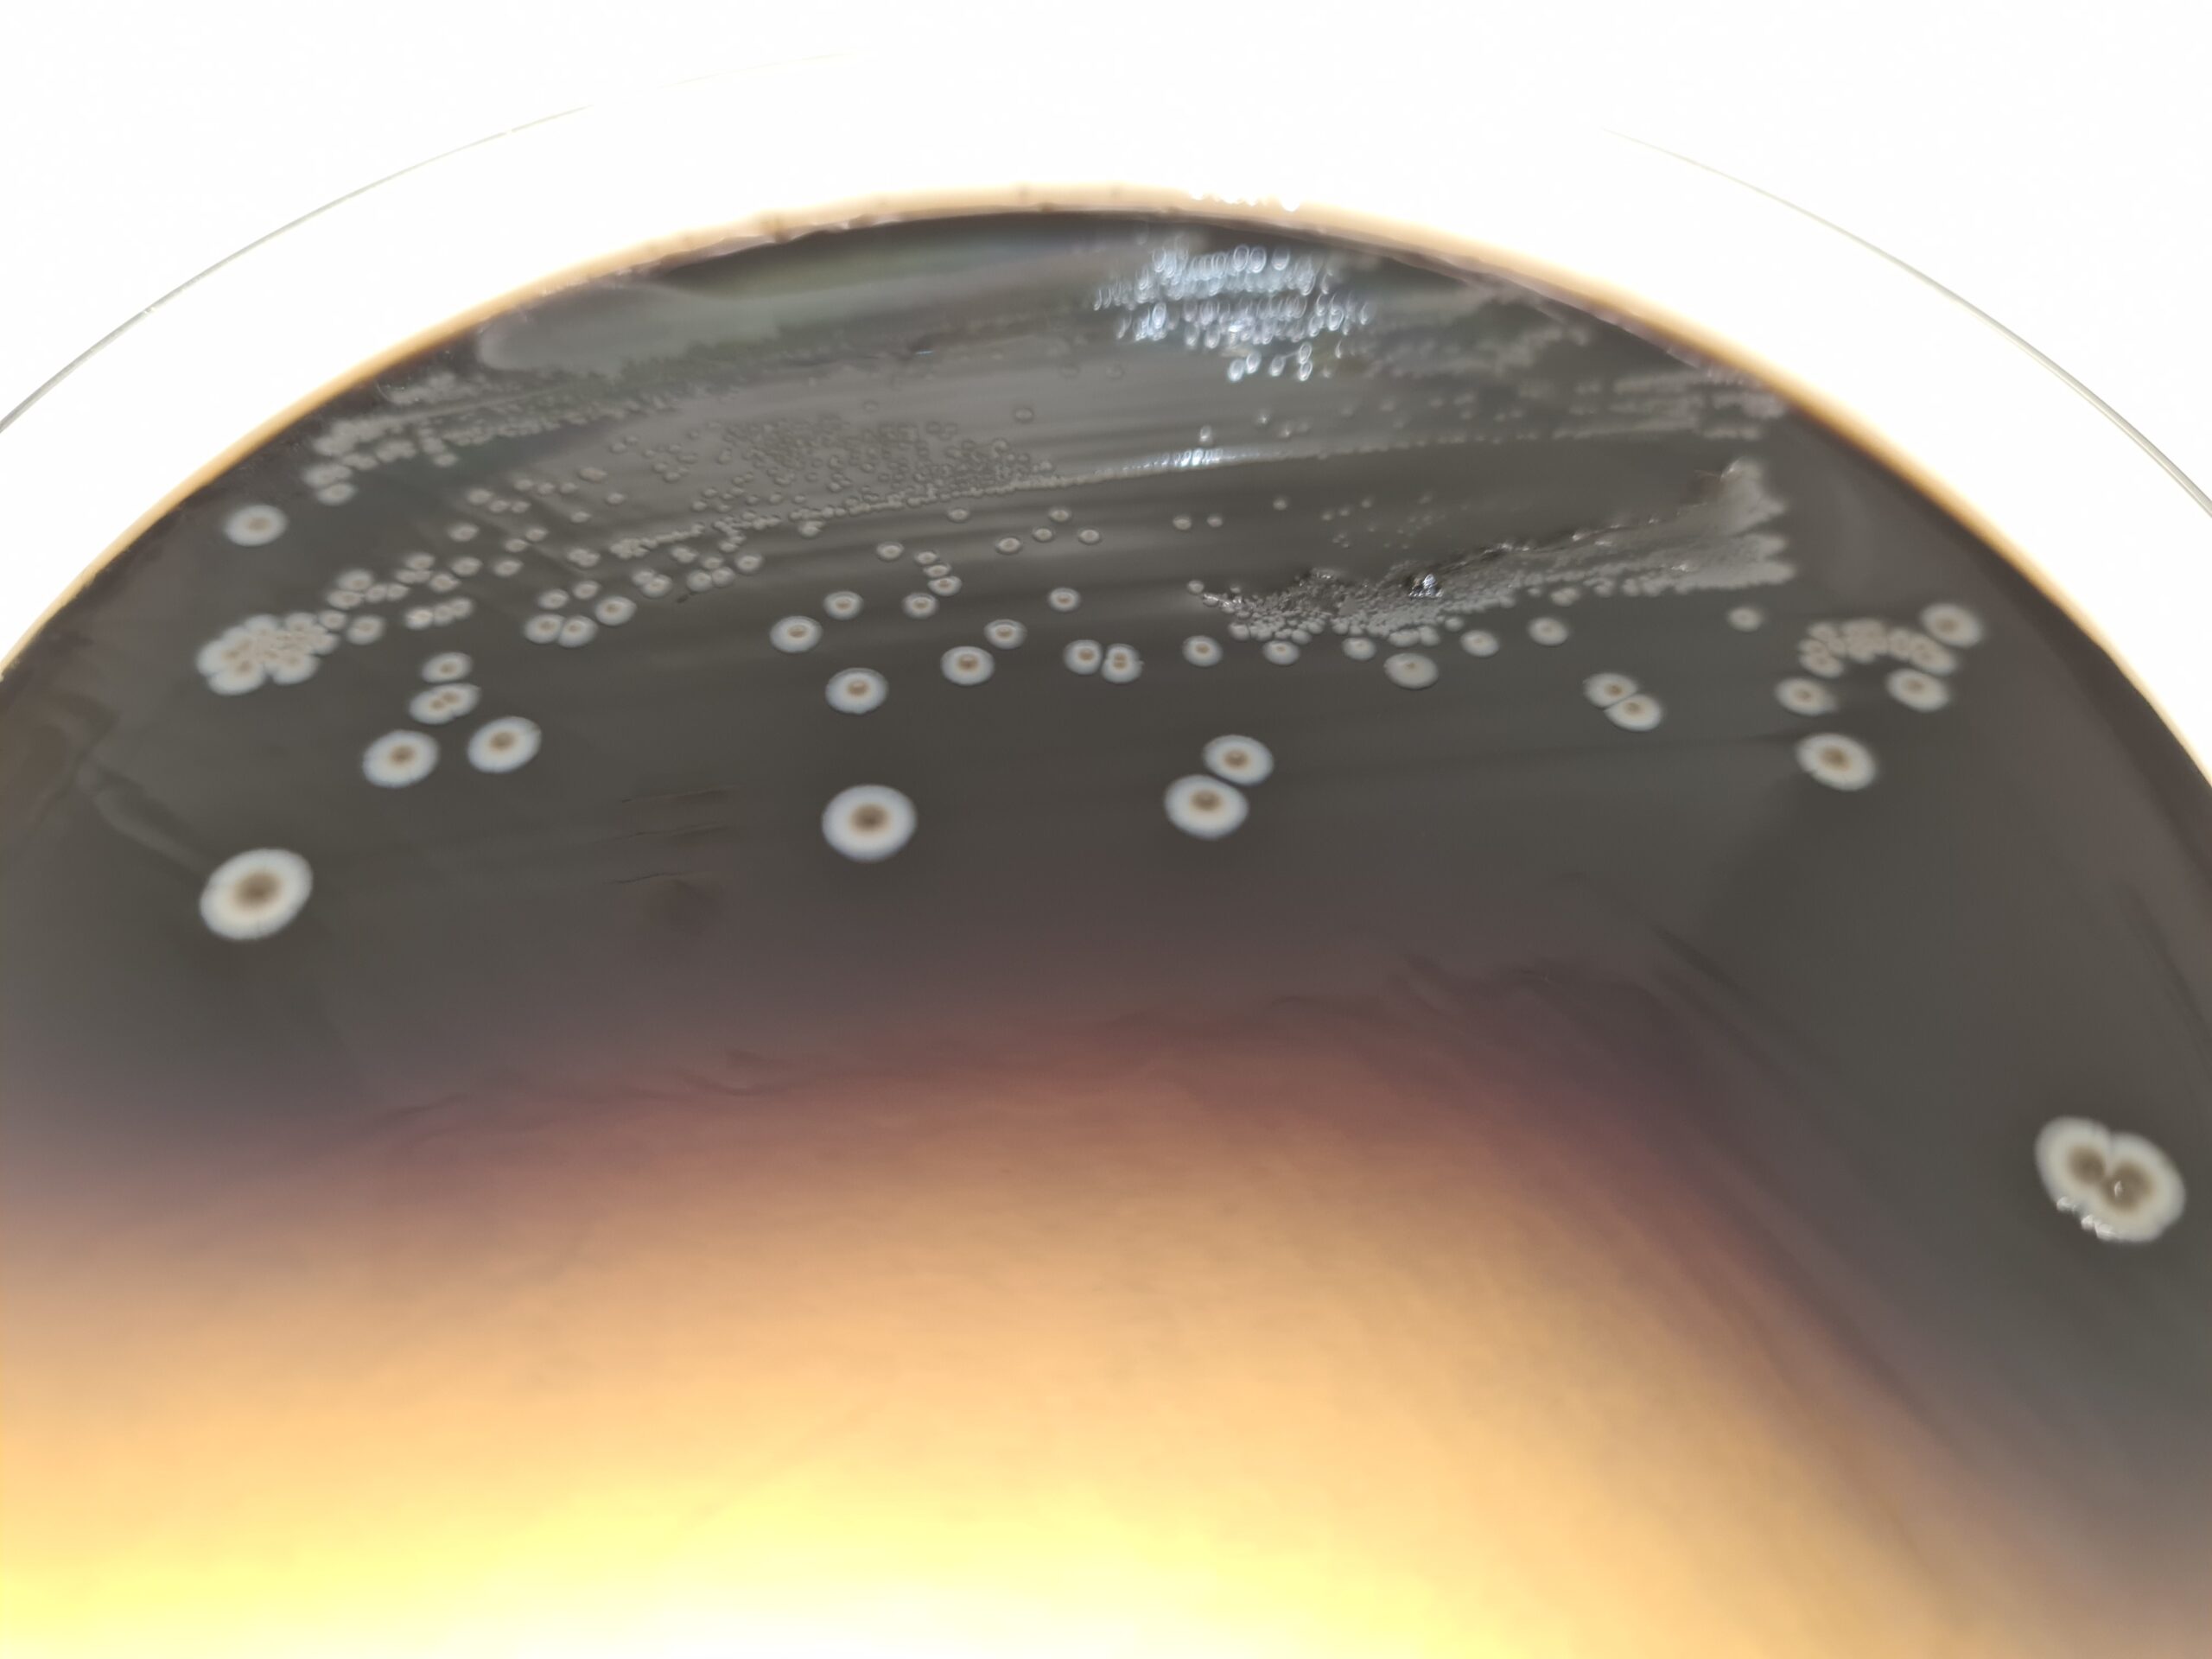
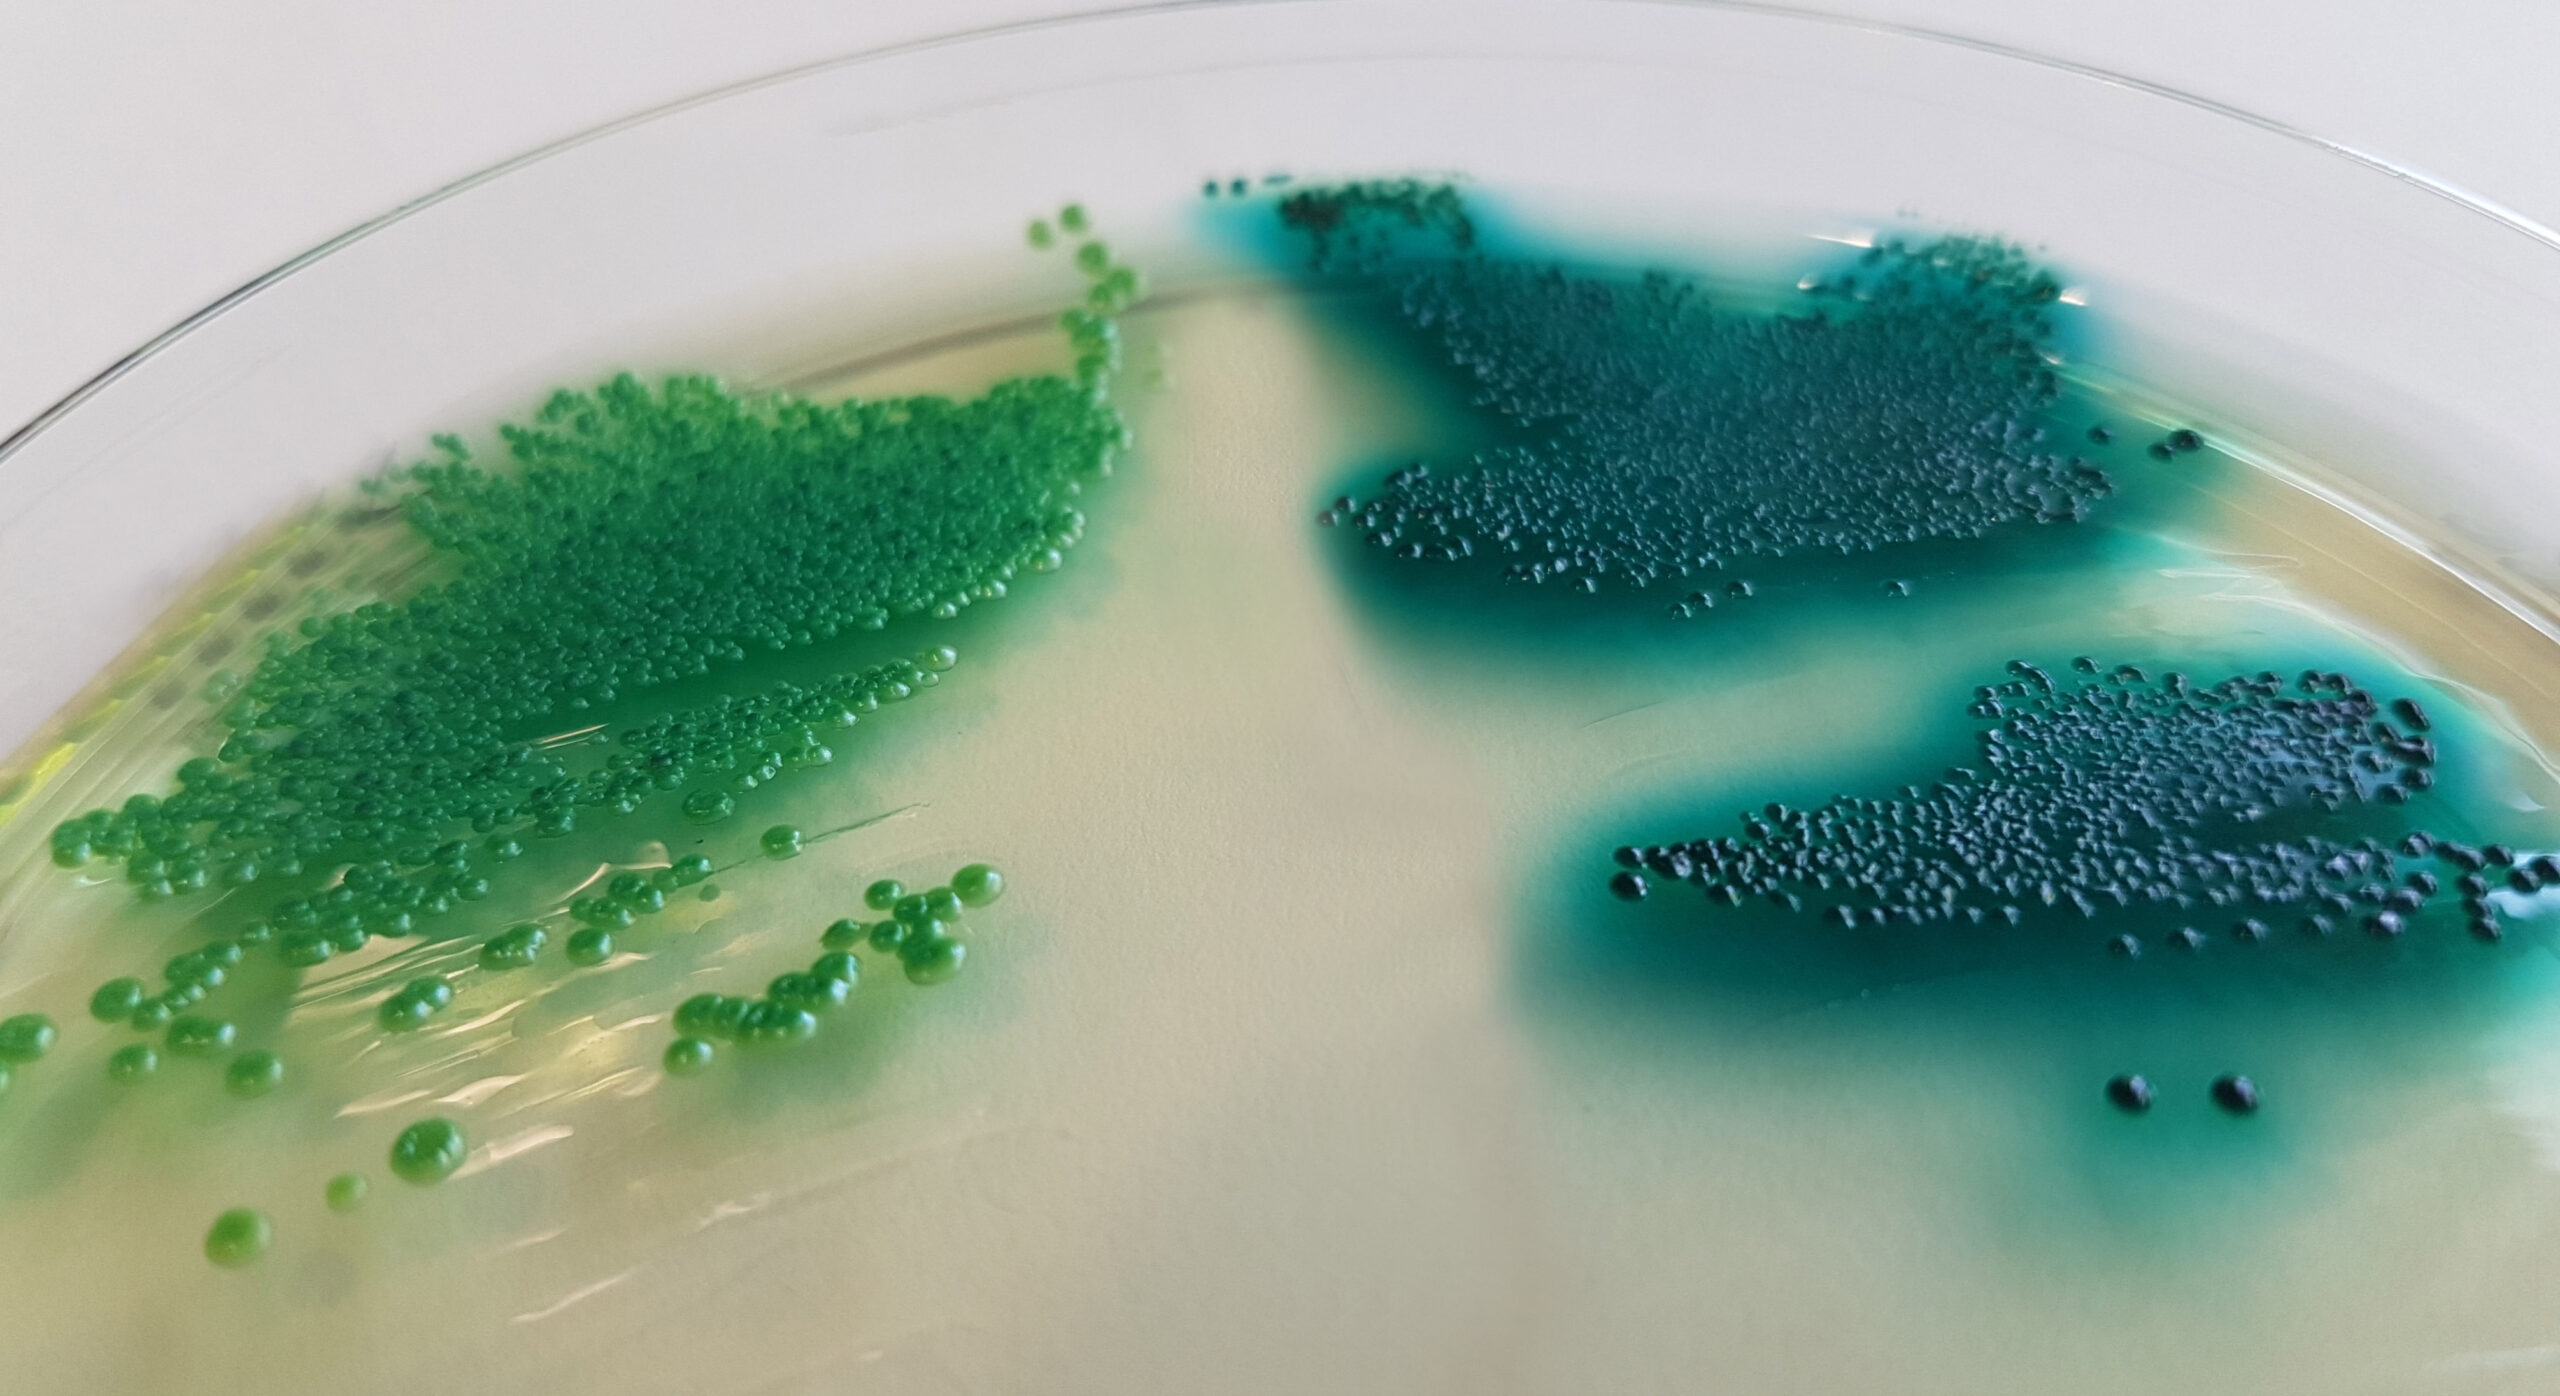
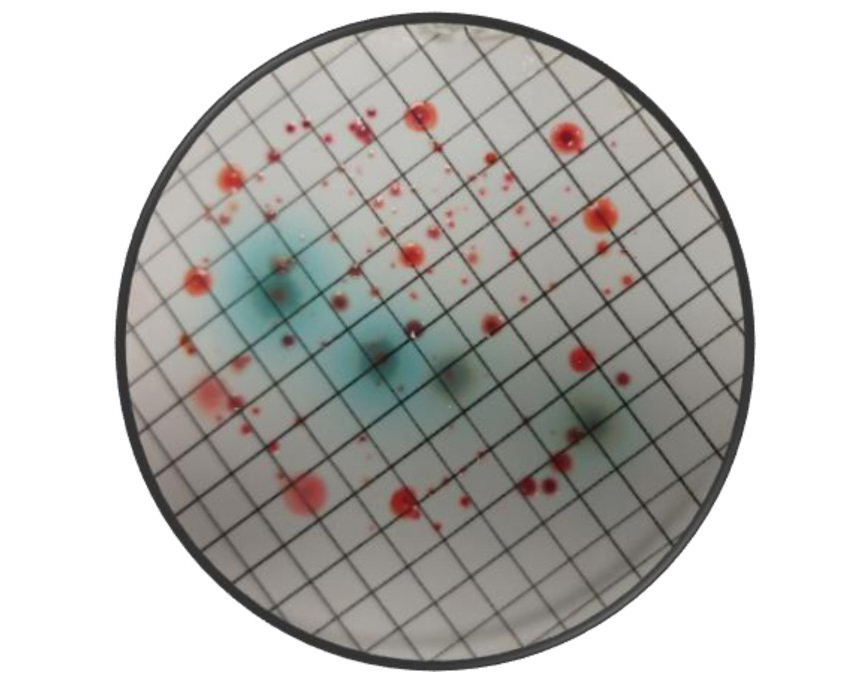
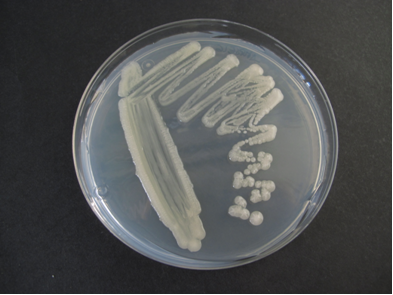
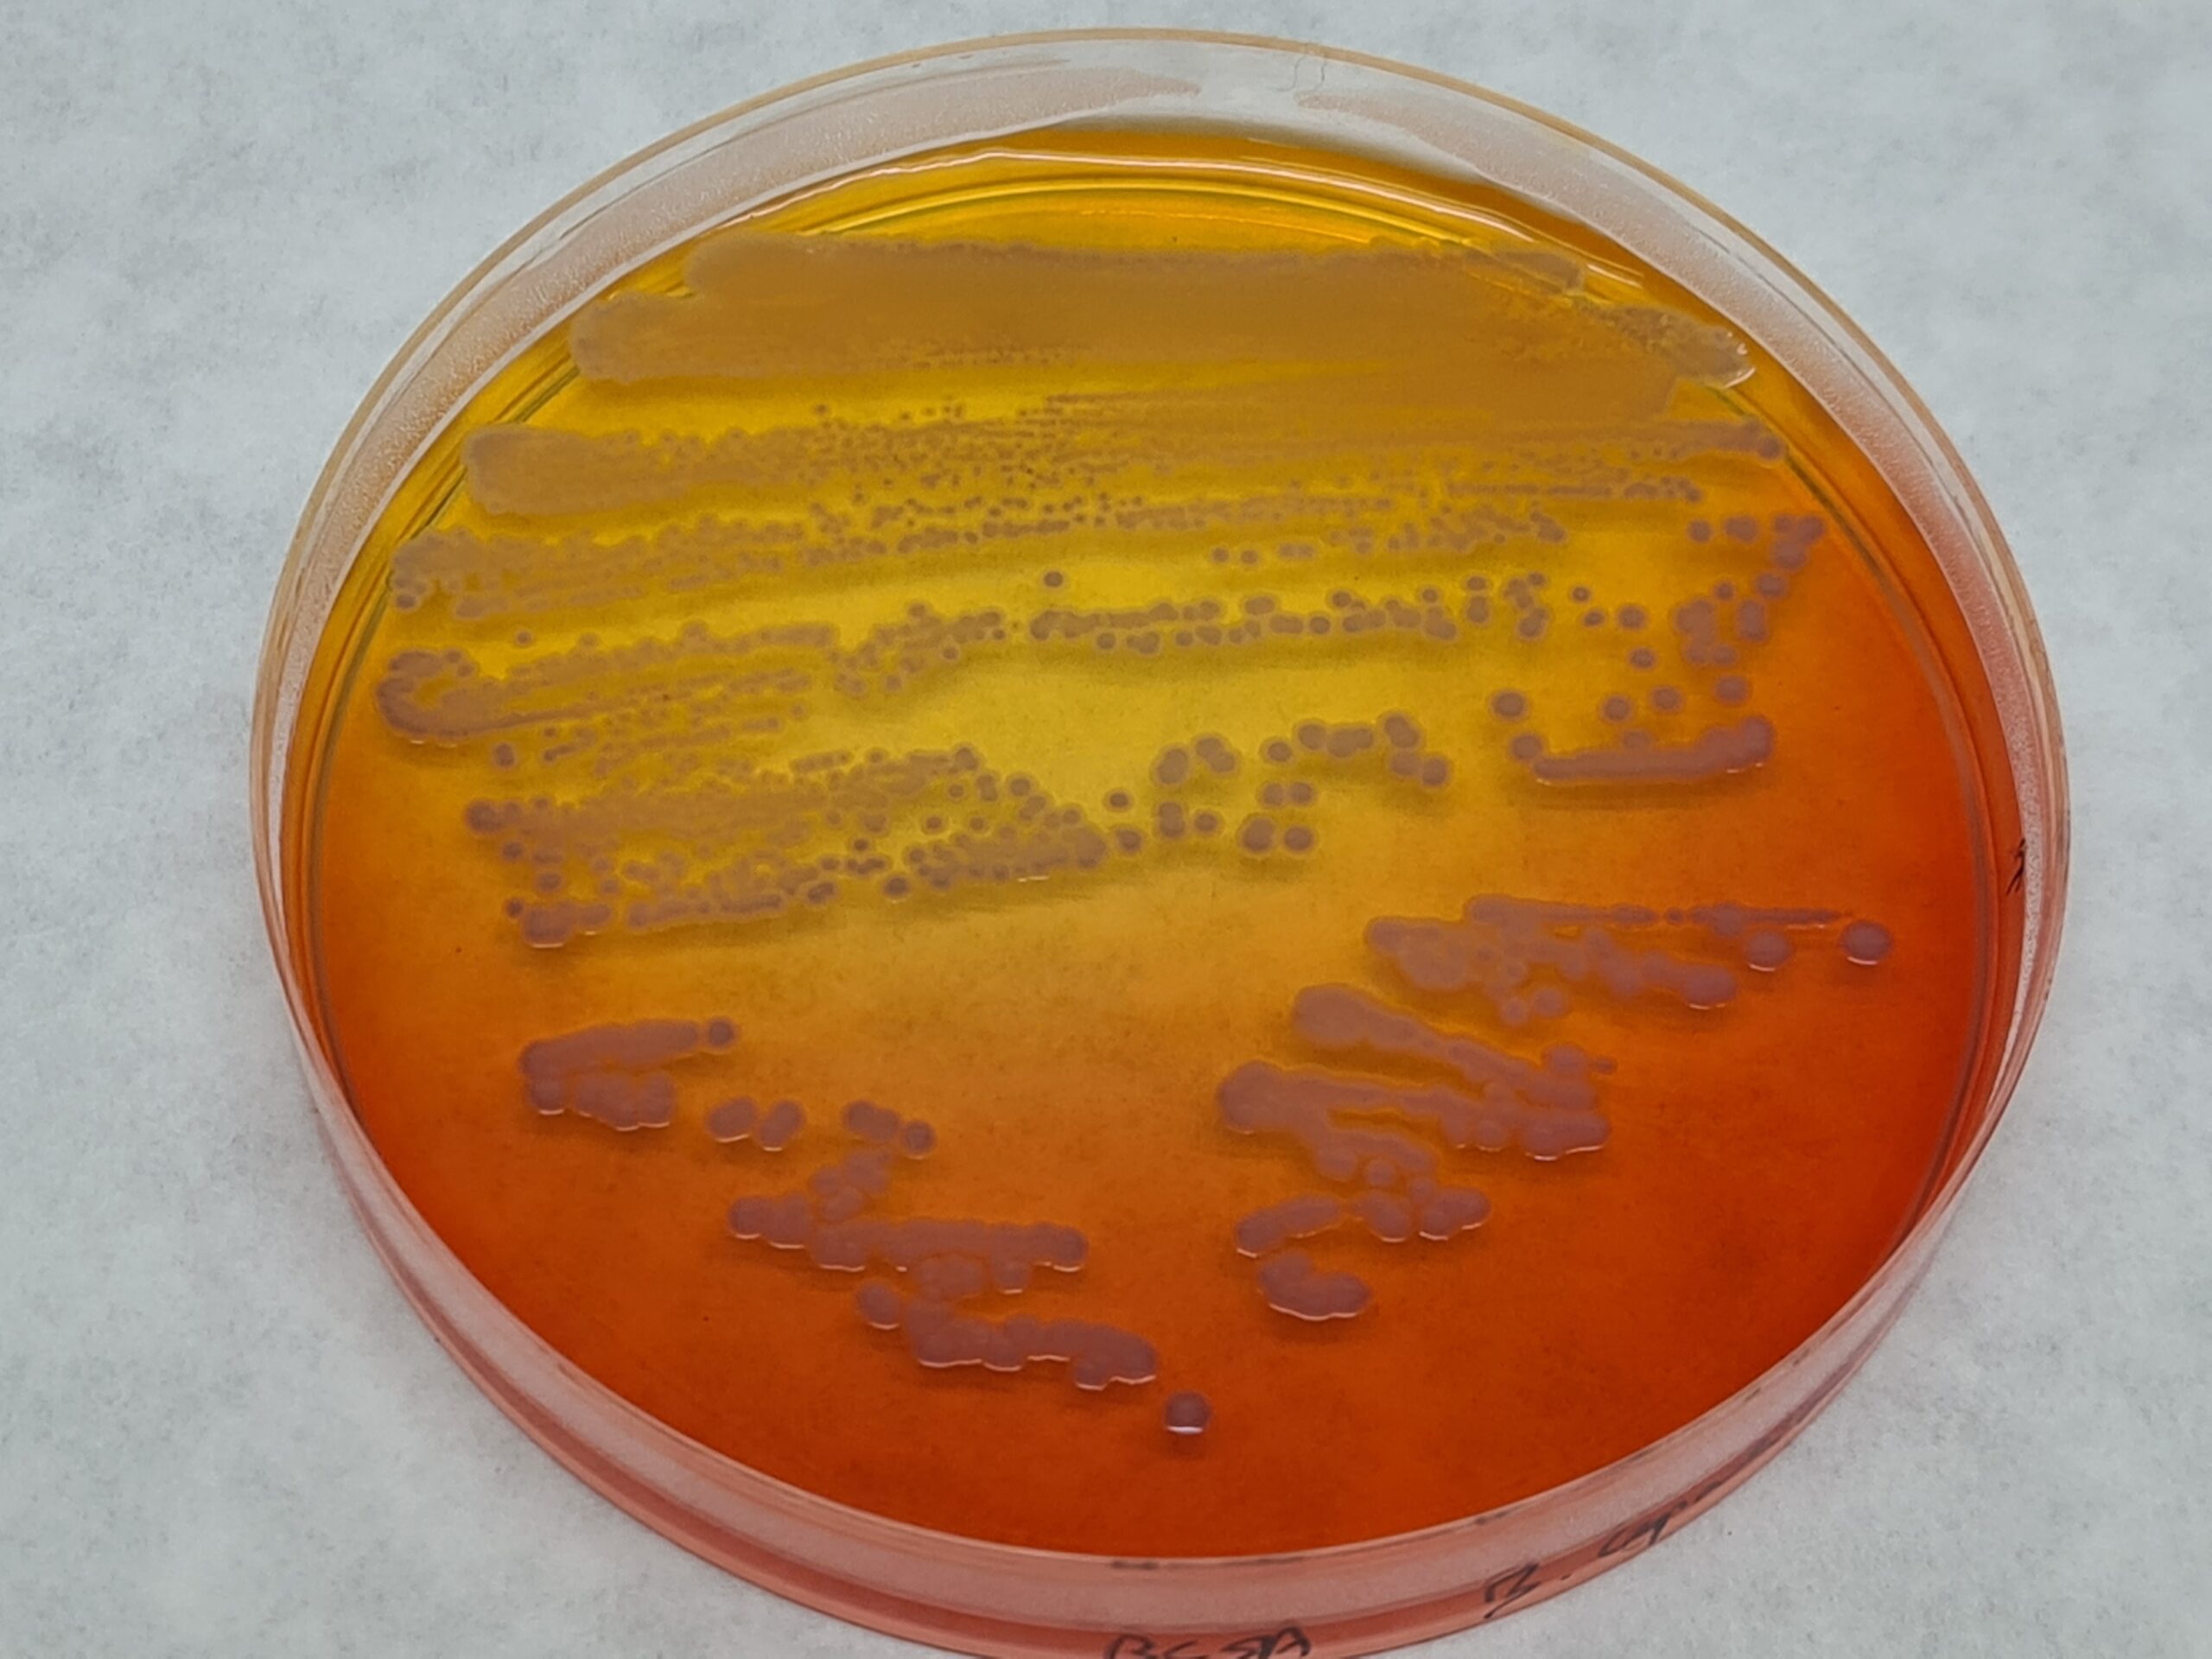
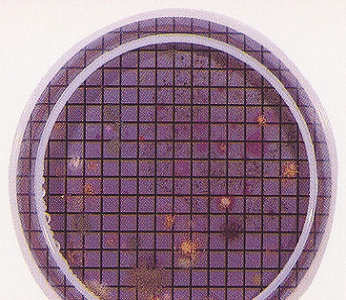

Medios de cultivo innovadores
Medios de cultivo innovadores: de la tradición a los avances de la ciencia en el siglo XXI ¿seguimos estancados o despegamos de una vez?
Presentamos una completísima lista de medios de cultivo, ordenados por el microorganismo afectado
Arriba de cada uno pondremos los medios clásicos disponibles en MICROKIT
Y debajo de ellos (letra azul) los que sólo encontrará en MICROKIT porque son innovaciones que hemos generado ante los mediocres resultados de muchos medios clásicos
La innovación te lleva a un nivel superior.
En MICROKIT hablamos de certeza en tus resultados:
Acidotermófilos/Alicyclobacillus (alterativos en zumos)
Acidotermófilos Alicyclobacillus YSG Broth, Acidotermófilos Osmotolerantes GPY Broth, BAT Agar
Aerobios/Bioburden/Esterilidad
Blood Agar, Brain Heart Infusion Agar y Broth, Eugon ISO Agar, LB Luria Agar, Heterotrophic HPC Agar, LB Lennox Broth, Nutrient Agar, Nutrient Agar DEV, Orange Serum Agar, Plate Coun Agar (PCA), PCA-Milk, R2A Farmacopea, Terrific Broth, Thioglicolato FTM Farmacopea, Thioglicolato alternativo Farmacopea, Total Charcoal Agar, Triptone Soy Agar (TSA) Farmacopea, Triptone Soy Broth (TSB) Farmacopea, TSB irradiado (Media Fills Farmacopea), WL Nutrient Agar, YEA Nutrient Agar (PCA Water ISO)
LPT Neutralizing Agar, LPT Neutralizing Purple Agar, MDA Agar, Orange Serum Caf.Agar, PCA cromogénico, PCA-Milk cromogénico, R2A cromogénico, TSA Maxim Agar, TSB Cromogénico irradiado, YEA (PCA Water) cromogénico
Ver tambien Oligotrofos y Microorganismos marinos
Aeromonas (patógeno acuático)
Aeromonas BSI-BGA Agar, GSP Agar
Algas microscópicas (alterativas en agua envasada)
Algae Agar (Clorofíceas, Rodofíceas, Diatomeas, Cianofíceas… + Suplemento),
Ver también Cianobacterias
Anaerobios
Reinforced Clostridial Agar Farmacopea, Schaedler Agar
Ver también Clostridios y Reductores del Sulfato
Bacillus
Crossley Milk Medium, Dextrosa Tryptona ISO Agar (DTA), Cepa cuantitativa B.subtilis,
Bacillus cereus
Bacillus cereus Mossel ISO Agar (PREP, MYP, + Suplemento yema polimixina), Cepa cuantitativa B.cereus
Cromokit Bacillus cereus Agar
Bacillus coagulans
B.coagulans (thermoacidurans) Agar (+Suplemento)
Bacillus sporothermodurans (HRS, alterativo en bricks UHT)
Bacillus sporothermodurans (HRS) Cromogenic Agar, Cromokit Rapid HRS Agar
Bacteriófagos (virus que destruyen bacterias)
Ver colífagos
Brettanomyces/Dekkera (alterativa del vino envejecido)
Bretta USAL Agar
Brochotrix (Listeriácea alterativa de la carne)
Brochotrix STAA Agar (+Suplemento)
Burkholderia (Patógeno del agua farma-cosmética)
BCPT Agar, BCSA Agar Farmacopea
Cromokit BCPT Agar
Campylobacter (Patógeno alimentario muy recuente)
Campylobacter Blood Free ISO Agar (CCDA + Suplementos), Campylobacter Selective Enrichment Preston ISO Broth
Cromokit Campy Agar
Candida (patógeno cosmético)
Biggy Nickerson ISO Agar, Corn Meal ISO Agar, Potato Dextrose ISO Agar (PDA)
BiggyPlus Agar, Cromokit Candida Agar (uso clínico, no recomendable en cosméticos), Rapid Sabouraud RYM Agar
Ver también Levaduras
Cianobacterias (toxigénicas en aguas de consumo y baño)
CianAgar
Ver también algas microscópicas
Clostridium botulinum (patógeno en conservas)
Agar Clostridium botulinum (+Suplementos)
Clostridium perfringens (patógeno en alimentos y aguas)
Buff.Nitrate-Movility ISO Medium (+ Suplementos), Lactose-Gelatin ISO Medium, Lactose-Sulfite ISO Broth, LENA ISO Agar (+ Suplementos) m-CP RD 1074Agar, RPM Fluid ISO Broth (+Suplementos), TSC MUP ISO Agar (+Suplementos), TSN Agar
Cromokit C.perfringens Agar
Clostridium sulfito-reductores
ISA (Sulfite Iron Wilson Blair ISO Agar), Dilución madre y diluciones ISO para ISA, SPS Agar
Clostridium tyrobutiricum (alterativo del queso)
Bryant Burkey Resazurin Broth
Colífagos somáticos (indicadores en aguas de consumo)
Bacteriófagos Scholten ISO Agar, ISO Broth y Semisolid ISO
Colífagos ARN F específicos (indicadores en aguas de consumo)
Bacteriófagos ARN F específicos ISO Agar, ISO Broth y Semisolid ISO (+Suplemento)
Coliformes (indicadores de higiene deficiente)
BGBL Brilliant Green 2% Broth, BGBL MUG, CCA ISO-MugPlus Agar, Desoxicolato Citrato DCA Agar Farmacopea, EC ISO Broth, EMB Levine ISO Agar, ENDO Agar y Broth MF, Lactose Broth Farmacopea, Lauryl Sulfate ISO Broth, MacConkey Agar, MacConkey Broth Purple Farmacopea, MFC Agar y Broth, Minerals Glutamate ISO Broth, MRVP Clarks & Lubs ISO Broth, VRBL ISO Agar, VRBL MUG Agar,
MUGPLUS Agar (CCA)
Cronobacter (patógeno alimentario en neonatos)
Cromokit Cronobacter sakazakii ISO Agar, Cromokit Cronobacter sakazakii CSA-DFI Agar, Cromokit Cronobacter sakazakii Enrichment ISO Broth
Ver también Enterobacterias
Dermatofitos (patógenos en playas, piscinas…)
DTM Caf Taplin Agar
Diluciones, Neutralización de conservantes…
Buffered Peptone ISO Water (BPW, APT), Buffered ClNa Peptone Solution pH 7 Farmacopea, Eugon ISO Broth, Letheen Broth, Líquido K Rinse (lavado de membranas filtrantes) Farmacopea, Maximum Recovery Diluent ISO (Peptone Saline), Neutralizing ISO Diluent SCDLP20, Nutrient Broth (caldo común), PBS Phosphate Buffered Saline ISO, Ringer ¼
Buffered Peptone Neutralizing Water, LPT Neutralizing Broth, LPT Neutralizing Purple Broth
E.coli (indicador de higiene deficiente)
EC ISO Broth, EMB ISO Levine Agar, ENDO Agar y Broth MF, Lactose Broth Farmacopea, Lauryl Sulfate ISO Broth, Lauryl Sulfate ISO Broth MUG, Lauryl Triptose Mannitol Rapid ISO Broth, LB Luria Agar, LB Lennox Broth, MacConkey ISO Agar, MacConkey Agar MUG, Terrific Broth, Tryptone-Tryptophan ISO Water, Tryptone Bile ISO Agar (TBA), TBX ISO Agar
Ver también Coliformes y Enterobacterias
E.coli O157 (patógeno de Riesgo 3 en aguas y alimentos)
Cromokit O157 ISO Agar, E.coli O157 ISO Broth, Nutrient O157 ISO Agar, Sorbitol McConkey ISO Agar (+Suplemento), MUGPLUS Agar
Enterobacterias (indicador de higiene deficiente)
Dextrosa Triptona Agar Yeast ISO Agar, EE Broth (Brilliant Green Bile Glucose Buff.Broth) Farmacopea, Hektoen Enteric ISO Agar, Kligler KIA ISO Agar, O/F Glucose ISO Medium, O/F Hugh-Leifson Medium, SIM Medium, Simmon’s Citrate Agar, Triple Sugar Iron ISO Agar (TSI), VRBG ISO (Agar)
Ver también Coliformes, Cronobacter, E,coli, Salmonella, Shigella, Yersinia…
Enterococos (indicador en aguas)
Bilis Esculina Azida ISO Agar (Rapid BEA), Cromokit EPA Agar, M-Enterococcus Slanetz-Bartley ISO Agar,
Rapid BEA
Estreptococos (indicador de higiene deficiente)
Azide Dextrose Rothe Broth, Ethyl Violet Azide (EVA) Litsky Broth, KAA Agar, KF Kenner Agar, M17 Agar, Todd Hewith Broth
Lactobacilos y demás Acidolácticas (alterativos en alimentos)
Bifidobacterium Agar, Homo/Heterofermentative Differential Agar, MRS ISO Agar y Broth, Pediococcus Broth, Tomato Juice Agar y Broth (TJA, TJB)
Cromokit Lactobacillus Agar
Legionella (patógeno agua-aire)
BCYE ISO Agar, GVPC ISO Agar
Levaduras y Mohos
Cloranfenicol Glucose ISO Agar (YGC), Dichloran Glicerol (DG18) ISO Agar, Dichloran Rosa Bengala (DRBC) ISO Agar, Malt Agar, Malt Extract Agar (MEA), OGYE Agar (+Suplemento), Orange Serum Agar (OSA), Potato Dextrose Agar (PDA), Rosa Bengala Caf Agar, Sabouraud Dextrose Agar SDA y Broth (SDB) Farmacopea, Sabouraud Caf Agar, Sabouraud Maltose Agar, WL Nutrient Agar, WL Differential Agar, Worth Agar y Broth (Mosto), YM Yeast Malt Broth
Cromokit Sabouraud Agar, Malt Extract Caf Agar, M-Green Caf Broth, Orange Serum Caf.Agar, Potato Dextrose Caf Agar, Rapid Sabouraud RYM Agar, Sabouraud Polimicological Broth
Ver también Brettanomyces, Candida, Dermatofitos, Osmófilos-Zygosaccharomyces
Lipolíticos (alterativos de mantequilla)
Tributyrin Agar
Listeria (patógeno en alimentos)
Cromocytogenes O&A ISO Agar (+Suplementos), LEB Lovett Broth, SemiFraser y Fraser ISO Broth(+Suplementos), Oxford ISO Agar (+Suplementos), Palcam ISO Agar (+Suplementos), Rhamnosa/Xylosa ISO Broth (+Suplementos), TSB-YE ISO Agar y Broth
Microorganismos marinos
Hierro Lyngby Marine Agar, Marine Total Ocean Agar, Marine Water (Ocean Salt)
Oligotrofos (microorganismos del agua en letargia)
R2A Farmacopea, YEA Nutrient Agar (PCA-Water ISO)
Cromokit R2A, Cromokit YEA (PCA-Water)
Ver tambien aerobios
Osmófilos/Osmotolerantes/Zygosaccharomyces (alterativos de zumos y concentrados)
Osmophylic Zygosaccharomyces Yeast Agar OZYA, Osmotolerant Yeast Agar OYA,
Patógenos varios
Cromokit CUP12 Cosmetic Pathogen Agar, Cromokit Pre-Ident Agar
Pseudomonas (patógeno del agua)
Acetamida ISO Broth (+Reactivo Nessler), Cetrimide Agar (+Glicerina) Farmacopea, CN ISO Agar (+Suplementos), King A Piocianin ISO Agar, King B Fluorescein ISO Agar, Lactose Magnesium Broth, Nutrient Pseudomonas ISO Agar
Cromokit Rapid Cetrimida Agar, Cromokit Rapid CN Agar
Reductores del sulfato (alterativos de combustibles fósiles y sus instalaciones)
Sulfate API Agar
Ver también Anaerobios y Clostridium
Rhizobium (simbionte agrícola)
Rhizobium USAL Agar
Salmonella (patógeno de alimentos, aguas, farmacosmética…)
Bismuth Sulfite Wilson-Blair ISO Agar, Brilliant Green ISO Agar, CromoSalm ABC ISO Agar, Lysine Iron Agar ISO (LIA) Agar, MK Tetrationato ISO Broth, Nutrient Agar ISO Salmonella, Nutrient Salmonella ISO Semisolid, Rappaport Vassiliadis Soy ISO Broth, Rappaport MSRV ISO Semisolid, Salmonella-Shigella ISO Agar, Selenito-Cystina ISO Broth, Urea ISO Agar y Broth, XLD ISO Agar
Salmonella-Shigella Broth
Ver también Enterobacterias
Shigella (patógeno de Riesgo 3 en aguas y alimentos)
GN Hajna Broth, Shigella ISO Broth
Salmonella-Shigella Broth
Ver también Enterobacterias
Staphylococcus aureus (patógeno de alimentos, aguas de baño, farmacosmética…)
Baird Parker ISO Agar (+ Suplemento Yema con telurito), DNA-asa Agar (Agar Termonucleasa con azul de toluidina), Giolitti-Cantoni ISO Broth, Mannitol Salt Agar Farmacopea, Vogel Johnson Agar
Baird Parker Cromogenic Agar (BPX19A), Baird Parker Mannitol Rapid Agar (BPMY), Mannitol Salt Broth
Sulfito-reductores
Ver Clostridium sulfito-reductores
Vibrio (patógenos de aguas y alimentos)
Alcaline V.cholerae ISO Broth, Alcaline-Saline V.parahaemolyticus ISO Broth, Nutrient ISO Vibrio Agar, TCBS ISO Agar, Vibrio TSAT ISO Agar (+Suplemento)
V.cholerae MPT Agar y Broth, Cromokit V.parahaemolyticus Agar, V.parahaemolyticus Hipersaline Agar y Broth,
Yersinia (patógeno alimentario)
CIN ISO Agar, Nutrient Yersinia ISO Agar
Ver también Enterobacterias
Zygosaccharomyces
Ver Osmófilos y Levaduras
Consulte los medios de cultivo de su interés solicitando información y precios actualizados en microkit@microkit.es
También puede descargar sus folletos, por sus nombres, en:
https://www.microkit.es/fichas-tecnicas-medios-de-cultivo.htm
y en: